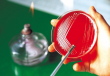
мазок на микрофлору

Анализы и исследования
Как производят подсчет лейкоцитов? Для того, чтобы определить количество лейкоцитов в биологической жидкости, анализ мочи исследуют при помощи микроскопа. При...
Лейкоциты – это разнообразные клетки крови человека или белые кровяные тельца (агранулоциты и гранулоциты), которые являются неотъемлемой частью иммунной...
Сбор мочи для анализа Правильный сбор мочи играет важную роль в достоверности анализа. Несколько правил, которые следует соблюдать: Моча собирается утром,...
Общая характеристика клинического анализа крови Что входит в данное исследование? Оно предусматривает подсчет всех клеток крови, оценку их формы и размеров,...
Основные типы лейкоцитов Лейкоциты объединяют в себе два типа клеток, которые разделяются на подтипы: Гранулоциты включают эозинофилы, фагоциты, базофилы....
Показания для сдачи мазка Определение флоры влагалища проводят в следующих случаях: когда женщина жалуется на жжение и вагинальный зуд, боли внизу живота; при...
Показания к проведению анализа Анализ мазка – это первый этап лабораторной диагностики гинекологических заболеваний. Взятие мазка осуществляется при...
RBC в анализе крови: что это такое? RBC – это аббревиатура, обозначающая абсолютное количество эритроцитов в 1 литре крови. Норма RBC зависит от пола и...
Обычно общий анализ мочи у ребенка включает определение следующих лабораторных показателей: характеризующих общие свойства (количество, цвет, прозрачность);...
WBC: что это? WBC в анализе крови означает не что иное, как абсолютное число лейкоцитов. Для удобства интерпретации их подсчитывают под микроскопом в мазке, а...

у МЕНЯ ВО РТУ ПРИВКУС КИСЛОГО. бОЛЬШЕ НИКАКИХ СИМПТОМОВ НЕТ. что это может быть?
Я принял роксеру 15мг и кардиомагнил 75 мг после этого у меня пульс стал очень редкий раньше...
Индийские джинерики — это полный развод. Рекламщики Соб + дак обрекают людей с циррозом на самый...
Мне 15 лет, у меня очень болит в правом подреберье, боль ужасная, обезбалевающее не помогают уже...